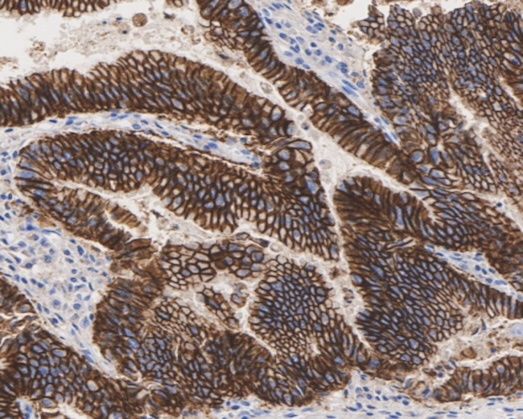

华安生物,凭借逾十年的专注深耕与持续创新,在高端工业级抗体领域构建了独具特色的技术平台与服务体系。我们深刻理解药物研发与精准诊断领域的复杂需求,致力于为工业客户提供从早期发现到规模生产的全链条、高性能抗体解决方案。
华安生物始终坚持以持续的技术创新和严格的品质管理作为立身之本。在病理IHC诊断抗体、配对抗体、ADC小分子检测抗体这三个专业赛道上,我们致力于将深厚的研发经验转化为客户可依赖的产品与服务,与合作伙伴共同推动生命科学探索与健康产业的进步。
在转化医学与疾病机制研究中,高质量的免疫组化(IHC)抗体是连接分子变异与组织表型的关键桥梁。华安生物(HUABIO)依托领先的哺乳动物细胞表达平台与深厚的病理学底蕴,专为福尔马林固定石蜡包埋(FFPE)组织开发并验证了一系列兼具高特异性、高亲和力与卓越批间一致性的高性能病理IHC诊断抗体。
我们建立的多维验证体系远超基础验证:每一支抗体均经过精心设计的组织微阵列(TMA)评估,涵盖广泛的正常组织与疾病病理组织,确保在复杂组织环境中的定位精准可靠。
我们的产品线全面覆盖肿瘤、神经退行性疾病、心血管疾病等关键领域的热门与新兴靶点,并配套提供实验方案优化与技术支持,帮助研究人员缩短方法建立周期,提升数据的可重复性与公信力,为生物标志物发现、药物作用机理研究及伴随诊断开发奠定坚实基石。
产品优势
Recommended Products
在体外诊断(IVD)领域,配对抗体的性能是决定试剂盒灵敏度、特异性与稳定性的核心。华安生物致力于为ELISA、化学发光、荧光免疫等主流平台提供高性能的配对抗体解决方案。我们认识到,成功的配对不仅仅是筛选两个结合力强的抗体,更是对表位空间分布、亲和力匹配度以及在不同检测平台上表现的系统工程。
我们的开发策略始于精准的表位图谱分析与空间位阻评估,确保筛选出的捕获抗体与检测抗体能够无干扰地同时结合目标抗原,形成稳定的"三明治"复合物。依托重组兔单抗等技术平台,我们从源头解决了批次一致性难题,为试剂盒大规模量产提供坚实保障。所有配对抗体均在真实检测环境的复杂基质(如血清、血浆)中进行严格验证,系统评估其检测下限、线性范围、钩状效应及对常见干扰物质的抗干扰能力。华安生物旨在成为IVD企业的核心原料伙伴,助力客户缩短研发周期,降低开发风险,确保产品长期质量稳定。
产品优势
Recommended Products
在抗体偶联药物(ADC)的药代动力学(PK)与安全性评估中,灵敏且特异地监测血液中微量游离毒素(Payload)是评估安全窗与优化连接子(Linker)技术的关键。华安生物聚焦行业前沿,打造了针对 MMAE、DM1、SN-38、Dxd 等主流毒素的高灵敏度、高特异性检测抗体。
开发此类抗体面临独特的高门槛:小分子毒素免疫原性极弱,且需精确区分游离毒素、连接子-毒素复合物及完整ADC。我们的技术突破在于创新的半抗原设计与偶联策略,通过精心设计保留毒素关键特征结构的免疫原,结合高效的动物免疫与筛选平台,能够获得针对目标小分子特定表位的高亲和力抗体。我们提供的不仅是一个抗体,更是一套完整的检测解决方案,包括方法学开发支持(如竞争ELISA、均相检测平台适配)以及符合法规要求的分析方法验证指导。这些工具能够助力ADC研发企业精确量化体内游离毒素的暴露水平,深入理解药物释放动力学,为临床前安全性评价和临床用药监测提供关键数据支持,从而加速更安全、更有效的ADC药物走向市场。
针对小分子免疫原性弱、区分难度大等挑战,我们通过创新的半抗原设计与位点特异性偶联策略,精准保留毒素的关键特征结构,结合重组单抗筛选平台,确保抗体具备极高的表位识别特异性与亲和力。我们不仅提供核心抗体,更提供一套完整的检测解决方案,包括方法学开发支持(如竞争法ELISA、均相检测平台适配)以及符合法规要求的分析方法验证指导。这些工具能够助力ADC研发企业精确量化体内游离毒素的暴露水平,深入理解药物释放动力学,为临床前安全性评价和临床用药监测提供关键数据支持,从而加速更安全、更有效的ADC药物走向市场。

浙公网安备 33019202000643号
浙公网安备 33019202000643号